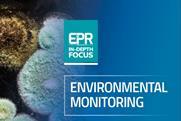
Screenshot 2026-04-14 132831

Bioprocessing and biomanufacturing
Discover advances in bioprocessing and biomanufacturing, from cell line development and upstream processing to downstream purification, scale-up, process optimisation and digital technologies that improve efficiency, product quality and commercial production outcomes.
Webinars and whitepapers
- Previous
- Next
Bioprocessing and biomanufacturing
Day three preview: the Future of Bio/Pharma Analysis Virtual Summit 2026
Pharmaceutical manufacturing takes centre stage on Day three of The Future of Bio/Pharmaceutical Analysis Virtual Summit 2026 as speakers examine how digital technologies, artificial intelligence and advanced production methods are reshaping what is possible in the field.
Implementing horizontal recycling for pharmaceutical release liners
Closed-loop backing paper recycling enables manufacturers to convert release liner waste into circular materials without modifications to existing printers or labellers, meanwhile ensuring EU packaging waste regulation compliance.
Troubleshooting capping defects in brittle tablet formulations
Cam-driven technology optimises the compaction process by maintaining consistent tablet hardness across turret speeds, enabling robust, scalable manufacturing of capping-prone blends.
What Annex 22 spells for AI in GMP manufacturing
Europe’s first dedicated framework for artificial intelligence in GMP manufacturing is close to finalisation and it is more demanding and more consequential than many manufacturers may currently appreciate.
Unlock exclusive industry insights
- Bookmark articles and resources to access anytime
- Enjoy free access to industry leading resources, webinars and insights
- Stay informed with the latest news and breakthroughs in drug discovery
- Receive updates and recommendations tailored to your research interests
Staying competitive within the evolving CDMO model
CEO of Lupin Manufacturing Solutions, shares his perspective on what differentiates credible CDMO entrants as pharmaceutical pipelines shift towards structurally complex molecules, the scientific imperatives shaping oncology and peptide manufacturing and the talent challenge that he believes will define competitive positioning in the decade ahead.
Breaking the biomanufacturing mould: a patient-centric CDMO approach
Helen Bickley, Chief Quality Officer, FUJIFILM Biotechnologies reveals a new agile approach to biologics production that adopts a modular strategy for greater flexibility and ease.
Real-time Raman spectroscopy closes bioprocess control measurement gap
Manual sampling cycles leave bioreactor control decisions hours behind culture dynamics. Process Raman spectroscopy offers continuous, real-time measurement of critical parameters, enabling true closed-loop control in perfusion and continuous bioprocessing applications where measurement lag directly impacts yield and product quality.
Process Raman spectroscopy: closing biomanufacturing’s measurement infrastructure gap
The biopharmaceutical industry has embraced Pharma 4.0 concepts, but the measurement infrastructure required to realise autonomous facilities and continuous bioprocessing remains underdeveloped. Process Raman spectroscopy offers continuous, non-destructive monitoring at frequencies aligned with cell culture dynamics, bridging the gap between control system capabilities and available data.
European Pharmaceutical Review Issue 1 (2026): Environmental Monitoring In-Depth Focus
This In-Depth Focus explores how BPCs, RMMs and AI-enabled analytics are being evaluated as a tool to enhance aseptic manufacturing, bioburden testing and monitoring.
European Pharmaceutical Review Issue 1 2026
EPR Issue 1 includes articles on manufacturing, drug delivery, environmental monitoring, analytical techniques and more.
Optimising the downstream process in lentiviral vector manufacturing
Sartorius BIA Separations illustrates a promising alternative approach for efficient lentiviral vector purification that delivers a scalable, GMP-ready biomanufacturing solution.
Pharma Horizons: Trends in Pharmaceutical Manufacturing
EPR’s 2026 pharma manufacturing trends report covers the key developments in supply chain, quality, drug development, new modalities and beyond.
Bioprocessing symposium to showcase biopharma and purification innovation
The three-day MSS2026 event takes place in September in Slovenia, with online attendance options also available.
The future of pharma R&D leadership
People, not platforms, will define the next era of innovation, explain Chiesi’s Executive VP of R&D Diego Ardigò and Nick Petschek, EMEA Managing Director at Kotter.
ReiThera on vaccines and remaining nimble around emerging threats
As vaccines are buffeted by political pressures, the CDMO discussed its growth approach and some of its key collaborations.
Fujifilm's Lars Petersen on trust-based partnerships and a ‘people first’ culture
Named CEO of the Year at CPHI Frankfurt, the CDMO’s head talks about the type of company he and his team are building.
A four-step way out of pharma manufacturing's asset management struggles
Here, Hexagon outlines a four-step plan to address silos and scale-up challenges, drawing on the experience of leading pharma firms like Pfizer.
A careful calibration: balancing small molecule needs and biologic innovation
CDMOs weigh up how to meet manufacturing demands across oral solid doses, monoclonal antibodies, ADCs and beyond.
HEATMOS filter technology for depyrogenation tunnels – innovations for extreme conditions
Nippon Muki demonstrates the performance advantages of its innovative HEPA filter for the sterilisation of injectable containers in pharmaceutical manufacturing.
European Pharmaceutical Review Issue 4 2025
EPR Issue 4 includes articles on manufacturing, AI/ML, vaccine development, biologics and more.
Why speed and flexibility matter now more than ever
The balance between speed, scale, and compliance has never been more critical. As GLP-1s, biosimilars, and advanced therapies reshape global priorities, pharma leaders face a new question: how can manufacturing infrastructure evolve fast enough to keep pace?
Optimising moisture and odour management in pharmaceutical packaging
This article answers some key questions about the need for environmental management in packaging, focusing on moisture and odour control, and the solutions available to achieve it.
European Pharmaceutical Review Issue 3 2025
EPR Issue 3 includes articles on microbiology, downstream processing, manufacturing, drug formulation and more.
Scaling for the GLP-1 revolution - meeting global injectable demand
In this article, Miguel Angel Ortega Sánchez of ROIS explores how the industry is adapting to new delivery formats, device bottlenecks, and strategic partnership models — and why flexibility, compliance, and tech transfer agility are now critical to success.
Pharma Horizons: leading-edge formulation
This report addresses the key factors shaping pharmaceutical formulation, including regulation, QC and analysis.
Breaking down silos - how digital tools can transform pharma manufacturing
Following their recent LinkedIn Live, Hexagon’s Adam Cross, Industry Director for Pharma and Life Sciences, reveals the state of data in pharmaceutical manufacturing, the opportunities available and how companies can ensure success and sustainable outcomes in their digitalisation journey.
Supporting the pharmaceutical industry – how a CDMO can help
After their recent webinar, European Pharmaceutical Review’s Head of Content Ian Betteridge spoke with the team at Adragos Pharma to discuss the role of a CDMO and their importance in the fill and finish sector.
A rapid microbiological method case study for advanced therapy medicinal products
In this article, Stacey Ramsey, Senior Manager – Microbial Applications Lab, Charles River Laboratories, discusses the modernisation of rapid microbiological methods (RMMs) and the potential of ATP-bioluminescence when testing cell-based products.